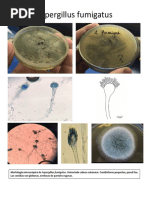

0% encontró este documento útil (0 votos)
346 vistas35 páginasColonias Bacterianas en Medicina Veterinaria
Este documento presenta información sobre diferentes géneros bacterianos importantes en medicina veterinaria, incluyendo Staphylococcus, Clostridium, Streptococcus, Bacillus, Escherichia coli y Salmonella. Describe las características morfológicas y de crecimiento de cada género y muestra imágenes de sus colonias en diferentes medios de cultivo como agar sangre y agar MacConkey.
Cargado por
Clarissa BustilloDerechos de autor
© © All Rights Reserved
Nos tomamos en serio los derechos de los contenidos. Si sospechas que se trata de tu contenido, reclámalo aquí.
Formatos disponibles
Descarga como DOCX, PDF, TXT o lee en línea desde Scribd
0% encontró este documento útil (0 votos)
346 vistas35 páginasColonias Bacterianas en Medicina Veterinaria
Este documento presenta información sobre diferentes géneros bacterianos importantes en medicina veterinaria, incluyendo Staphylococcus, Clostridium, Streptococcus, Bacillus, Escherichia coli y Salmonella. Describe las características morfológicas y de crecimiento de cada género y muestra imágenes de sus colonias en diferentes medios de cultivo como agar sangre y agar MacConkey.
Cargado por
Clarissa BustilloDerechos de autor
© © All Rights Reserved
Nos tomamos en serio los derechos de los contenidos. Si sospechas que se trata de tu contenido, reclámalo aquí.
Formatos disponibles
Descarga como DOCX, PDF, TXT o lee en línea desde Scribd